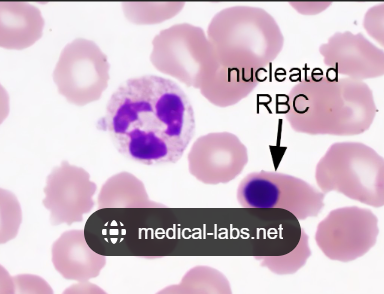

Function of each:
1. Neutrophil
2. Eosinophil
3. Monocyte
4. T-Lymphocytes (in peripheral blood)
5. B-Lymphocytes (in lymph nodes)
Hint: Don’t say “apart of inflammation”
- Phagocytize & destroy foreign particles with chemicals such as H2O2.
- Fight parasites & lead allergic reactions.
- Phagocytize foreign material & present antigen to lymphocytes.
- Lymphs can’t function without them!
- Mono’s in tissue are called Macrophages - Cellular immunity.
- Against infected cells or cancer. - Produce antibodies.
Features of malignancy (5)
- High N:C ratio
- Large nucleus to Small cytoplasm. - Mitotic figures
- Cells beginning or in the midst of mitosis. - Multiple nucleoli in nuclei
- Bizarre variable nuclei in cell population with open chromatin
- Anisocytosis
Features of inflammation (2)
- Presence of neutrophils, eosinophils, or macrophages in sample at numbers greater than peripheral blood.
- Infectious organisms present.
- Especially inside of neutrophils or macrophages.
Features of Regenerative anemia (4)
- Nucleated RBCs
- Immature RBCs still containing a nucleus. - Reticulocytes
- Larger & bluer on diff quik. Dots on new methylene blue. - Polychromasia
- Anisocytosis.
And NOTHING else!
Unit for total protein
8.0____
8.0gm/dL
Report to the tenths!
Unit used when doing CBC
26,000____
26,000wbc/uL
”/” needs to be included for numbers per volume!
T/F: In regard to urine sediment, specifying Calcium oxalate monohydrate & Calcium oxalate dihydrate isn’t necessary.
False!
Monohydrate and Dihydrate are different and require dramatically different care!
- Monohydrate = ethylene glycol poisoning
- Dihydrate = breed related diet processing
- What is the average size of a urine cast?
- What objective could they be seen on?
- At least two RBCs wide and 4-20 RBCs long.
- Easily on LPF
What are “toxic” lymphocytes?
Trick question, there’s no such thing!
REACTIVE lymphocytes might be what you’re thinking of.
Reactive lymphocytes are a sign of what?
Inflammation
- Not malignancy
What causes cell clusters?
Sample technique
- In tissue all cells stick together.


